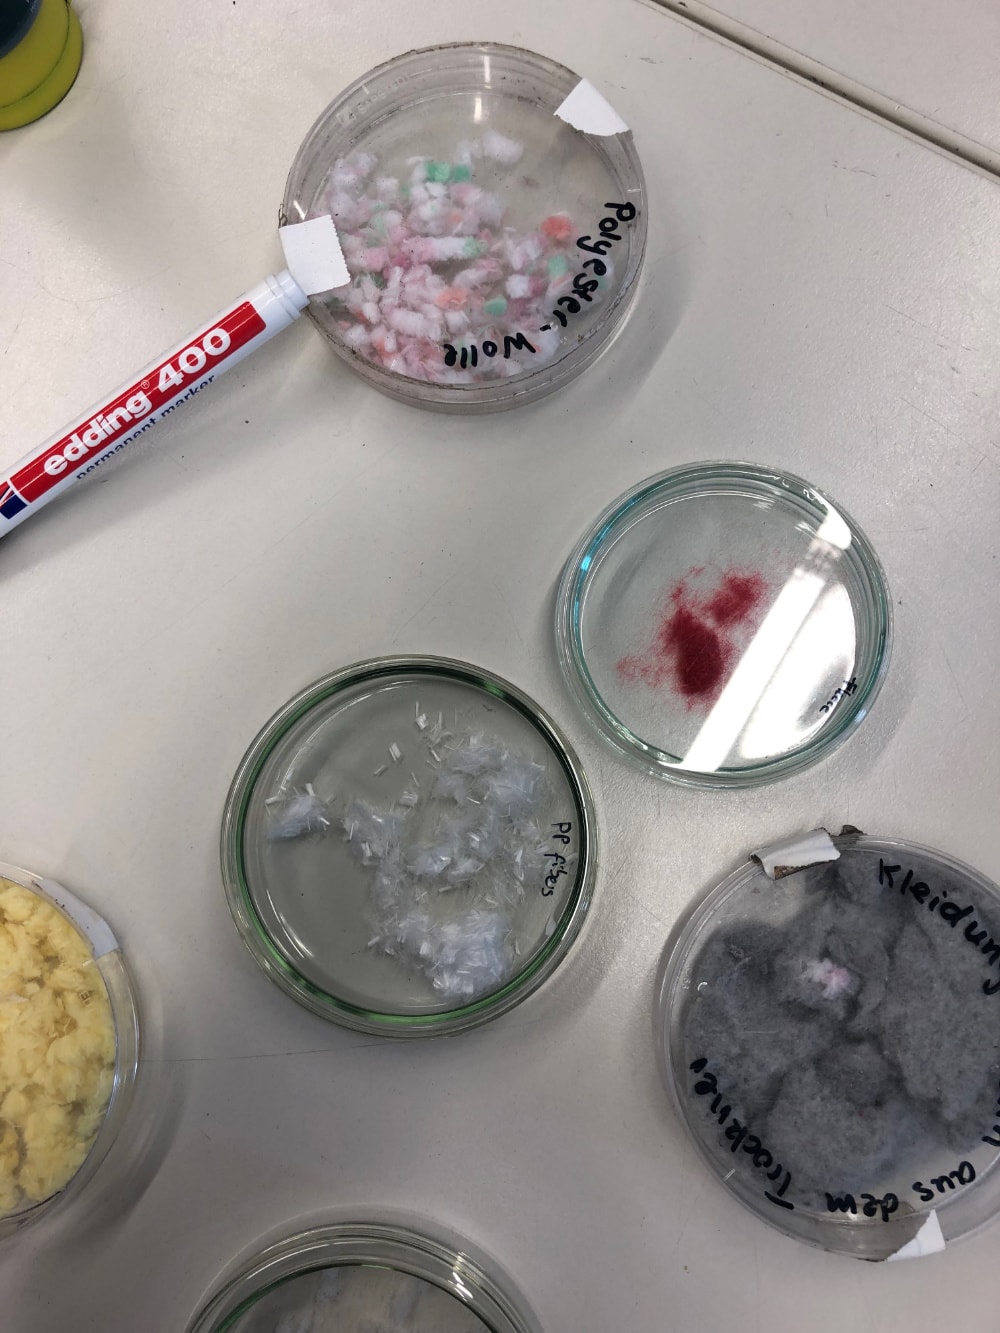

Das viertägige Festival MATTER OF FLUX präsentiert ein reichhaltiges und abwechslungsreiches Programm von und für Frauen/ FLINTA* in Kunst, Wissenschaft und Technologie mit Podiumsdiskussionen, Lecture Performances, zahlreichen Workshops, Lesegruppen und anderen Aktivitäten, darunter auch Besuche in Ausstellungen, Künstlerinnenateliers und Labore. Das Festival wird unterstützt durch das Programm Neustart Kultur von Kunstfonds und findet in Kooperation mit FEMeeting statt.
Das MATTER OF FLUX Festival findet im Rahmen der Gruppenausstellung MATTER OF FLUX statt. Die vielfältigen Formate und Veranstaltungen des Festivalprogramms basieren auf den reichhaltigen Ergebnissen mehrerer Vorbereitungstreffen bei Art Laboratory Berlin im Jahr 2023. Mehr als 40 internationale, in Berlin lebende Frauen/ FLINTA* – Künstlerinnen, Kulturschaffende und Wissenschaftlerinnen aus Kunst, Wissenschaft und Technologie aus dem Globalen Norden und dem Globalen Süden – wurden eingeladen, gemeinsam verschiedene CLUSTER-Gruppen und Aktivitäten für das Festival zu entwickeln.
Sechs Cluster – CRITICAL HISTORY OF TECHNOLOGY, LEAKY CYCLES, TECHNOLOGIES/ SENSORS/ INTERFACES, PLANT ENCOUNTERS, ALTERNATIVE KNOWLEDGE PRODUCTION und HYDRO-RELATIONS – bieten während der vier Tage Workshops, Vorträge, Performances, Zine-making Lounges und mehr an. Darüber hinaus gibt es einen SMELL-Workshop sowie Atelier-, Ausstellungs- und Laborbesuche.
Das Festival fungiert als interaktive Plattform und lädt andere internationale oder in Berlin ansässige Frauen/ FLINTA* aus den Bereichen Kunst, Wissenschaft und Technologie ein, sich auszutauschen und Synergien zu schaffen. Art Laboratory Berlin hat begonnen, ein MATTER OF FLUX Netzwerk von und für Frauen/ FLINTA* zu schaffen, um in naher und ferner Zukunft ein größeres fortlaufendes Programm aufzubauen.
Mit Beiträgen von Künstlerinnen, Kulturproduzentinnen und Natur- und Geisteswissenschaftlerinnen:
Alanna Lynch, Alice Cannava, Anne Hölck, Annika Haas, Asian Feminist Studio for Art and Research (AFSAR), Aslı Dinç, Baldeep Kaur, Cansu Tekin, Cammack Lindsey, Charmaine Poh, Chiara Garbellotto, Constanza Piña Pardo, Eva-Fiore Kovacovsky, Flo Razoux, Gülşah Mursaloğlu, Hanwen Zhang, India Mansour, Jacky Hess, Jemma Woolmore, Käthe Wenzel, Kristina Stallvik, Lena Fließbach, Lena Johanna Reisner, Lisa Bell Weisdorf, Lucy Powell, Lyndsey Walsh, Marianna Szczygielska, Margherita Pevere, Mooni Perry, Nayeli Vega, Nicol Rivera Aro, Nicola Maria Hochkeppel, pamela varela, Park Hye-in, Petja Ivanova, Sarah Hermanutz, Selen Solak, Sina Ribak, Susanne Schmitt, Susanne Jaschko, Sybille Neumeyer, Theresa Schubert, WhiteFeather Hunter, Yan Lin.
Das ausführliche Festival Programm mit Abstracts und Biographien ist HIER erhältlich!
cluster ALTERNATVE KNOWLEDGE PRODUCTION, photo: Jan Bechberger
ALCHEMIC COOKING, cluster PLANT ENCOUNTERS – PRACTICES, SITES, COMMUNICATION, photo: Sina Ribak
MicroCosMOSS, cluster PLANT ENCOUNTERS – PRACTICES, SITES, COMMUNICATION, photo: Susanne Jaschko
OCTOPUSSYNTRIC, cluster TECHNOLOGIES, SENSORS, INTERFACES, photo: Nicol Rivera Aro
Cluster CRITICAL HISTORY OF TECHNOLOGY, photo: Baldeep Kaur
VESSELS FOR WATER, cluster HYDRO-RELATIONS, photo: Jemma Woolmore
FESTIVAL PROGRAMM | Übersicht (mit Bildern)
Das Festival findet an allen vier Tagen bei PA58 statt (Prinzenallee 58, 13359 Berlin, gegenüber von ALB), ausgenommen Atelier-, Labor und Ausstellungsbesuche, sowie Clubnacht.
Donnerstag, 15. Juni 2023 @ PA58
Festival Ort: PA58, Prinzenallee 58, 13359 Berlin (gegenüber von ALB)
TAGESPASS HIER ERHÄLTLICH (DIE ANMELDUNG FÜR DIE EINZELNEN VERANSTALTUNGEN BEGINNT AM MORGEN DESSELBEN TAGES VOR ORT)!
9:15 – 9:45 Registrierung vor Ort (auch für die Nachmittags-Veranstaltungen!)
10:00
MATTER OF FLUX Einführung
Regine Rapp (Art Laboratory Berlin)
Tuçe Erel (Art Laboratory Berlin)
Dalila Honorato (FEMeeting)
10:30 – 11:45
MATTER OF FLUX Paneldiskussion
WhiteFeather Hunter (artist, researcher, Perth) – The Witch in the Lab Coat
Lyndsey Walsh (artist, researcher, Berlin) – SELF-CARE
Moderiert von Regine Rapp (Kunsthistorikerin, Kuratorin, Art Laboratory Berlin)
11:45 – 12:45
CRITICAL HISTORY OF TECHNOLOGY Lecture Performance
Presentation of the AFSAR (Asian Feminist Studio for Art and Research) Reading Group with Charmaine Poh (Künstlerin, Berlin/Singapore), Hanwen Zhang (Kuratorin, Forscherin, Berlin/ China), Park Hye-in (Kuratorin, Berlin/ Seoul), Mooni Perry (Künstlerin, Berlin/ Seoul) and Yan Lin (Autorin, Berlin / Pingtan, China)
— 13:00 – 14:00 MITTAGSPAUSE —
Veranstaltungen zur Auswahl (morgens vor Ort registrieren)
14:00 – 15:30
LEAKY CYCLES Reading Group
India Mansour (Biologin, Berlin), Gülşah Mursaloğlu (Künstlerin, Berlin), Cammack Lindsey (Künstlerin, Sängerin, Berlin), Sybille Neumeyer (Kuratorin, Forscherin, Berlin), Lena Fließbach (Kuratorin, Berlin), Cansu Tekin (Biologin, Berlin)
14:00 – 17:00
TECHNOLOGIES/ SENSORS/ INTERFACES OCTOPUSSYNTRIC Workshop (Teil 1 von 2)
Constanza Piña Pardo (Künstlerin, Tänzerin, Forscherin, Berlin/ Chile), Nicol Rivera Aro (Kuratorin, Forscherin, Dramaturgin, Berlin/ Chile), pamela varela (Künstlerin, Activistin, Poetin, Berlin/ Mexico), Flo Razoux (Biologin, Dozentin, Berlin/ Marseille)
16:30 – 18:00
PLANT ENCOUNTERS. PRACTICES, SITES, COMMUNICATION Alchemic Cooking
Chiara Garbellotto (Anthropologin, Berlin), Sina Ribak (Forscherin, Berlin)
17:00 – 18:30
CRITICAL HISTORY OF TECHNOLOGY Zine Making Workshop (Teil 1 von 2)
Selen Solak (Experimentelle Forscherin, Berlin), Marianna Szczygielska (Forscherin für Feministische Wissenschaftsgeschichte), Baldeep Kaur (Forscherin für Englische Literatur und Science & Technology Studies, Berlin), Hanwen Zhang (Kuratorin, Forscherin, Berlin/ China)
14:00 – 18:00 Laufende Veranstaltungen
LEAKY CYCLES COMPOST Zine Lounge
India Mansour (Biologin, Berlin), Gülşah Mursaloğlu (Künstlerin, Berlin), Cammack Lindsey (Künstlerin, Sängerin, Berlin), Sybille Neumeyer (Kuratorin, Forscherin, Berlin), Lena Fließbach (Kuratorin, Berlin), Cansu Tekin (Biologin, Berlin)
ALTERNATIVE KNOWLEDGE PRODUCTION Instant Storytelling sessions
Anne Hölck (Szenographin, Kuratorin, Berlin), Nicola Maria Hochkeppel (Kulturproduzentin, Gesundheitsberaterin, Berlin), Petja Ivanova (Künstlerin, Dozentin, Berlin), Aslı Dinç (Künstlerin, Forscherin, Berlin)
ALTERNATIVE KNOWLEDGE PRODUCTION The Fluxional Shelf
Kristina Stallvik (Künstlerin, Forscherin, Berlin/ New York)
18:30
Empfang @ Art Laboratory Berlin für MoF Festival-Teilnehmerinnen
ZAHLREICHE BILDER vom Donnerstag, dem ersten Festival-Tag:
WhiteFeather Hunter, Lyndsey Walsh: MATTER OF FLUX, panel discussion, moderated by Regine Rapp, festival MATTER OF FLUX, Art Laboratory Berlin, 2023, photo: ALB
Lyndsey Walsh: MATTER OF FLUX, panel discussion, moderated by Regine Rapp, festival MATTER OF FLUX, Art Laboratory Berlin, 2023, photo: ALB
Regine Rapp, introducing the MATTER OF FLUX panel discussion, festival MATTER OF FLUX, Art Laboratory Berlin, 2023, photo: ALB
WhiteFeather Hunter: MATTER OF FLUX, panel discussion, moderated by Regine Rapp, festival MATTER OF FLUX, Art Laboratory Berlin, 2023, photo: ALB
WhiteFeather Hunter, Lyndsey Walsh: MATTER OF FLUX, panel discussion, WhiteFeather Hunter speaking, moderated by Regine Rapp, festival MATTER OF FLUX, Art Laboratory Berlin, 2023, photo: ALB
AFSAR (Asian Feminist Studio for Art and Research), lecture performance, script by Charmaine Poh, Hanwen Zhang, Park Hye-in, Mooni Perry, Yan Lin, Musquiqui Chihying, You Feng, Eugene Hannah Park, festival MATTER OF FLUX, Art Laboratory Berlin, 2023, photo: Isabelle Schmitz
AFSAR (Asian Feminist Studio for Art and Research), lecture performance, script by Charmaine Poh, Hanwen Zhang, Park Hye-in, Mooni Perry, Yan Lin, Musquiqui Chihying, You Feng, Eugene Hannah Park, festival MATTER OF FLUX, Art Laboratory Berlin, 2023, photo: Isabelle Schmitz
AFSAR (Asian Feminist Studio for Art and Research), lecture performance, script by Charmaine Poh, Hanwen Zhang, Park Hye-in, Mooni Perry, Yan Lin, Musquiqui Chihying, You Feng, Eugene Hannah Park, festival MATTER OF FLUX, Art Laboratory Berlin, 2023, photo: Isabelle Schmitz
AFSAR (Asian Feminist Studio for Art and Research), lecture performance, script by Charmaine Poh, Hanwen Zhang, Park Hye-in, Mooni Perry, Yan Lin, Musquiqui Chihying, You Feng, Eugene Hannah Park, festival MATTER OF FLUX, Art Laboratory Berlin, 2023, photo: Isabelle Schmitz
AFSAR (Asian Feminist Studio for Art and Research), lecture performance, script by Charmaine Poh, Hanwen Zhang, Park Hye-in, Mooni Perry, Yan Lin, Musquiqui Chihying, You Feng, Eugene Hannah Park, festival MATTER OF FLUX, Art Laboratory Berlin, 2023, photo: Isabelle Schmitz
AFSAR (Asian Feminist Studio for Art and Research), lecture performance, script by Charmaine Poh, Hanwen Zhang, Park Hye-in, Mooni Perry, Yan Lin, Musquiqui Chihying, You Feng, Eugene Hannah Park, festival MATTER OF FLUX, Art Laboratory Berlin, 2023, photo: Isabelle Schmitz
Chiara Garbellotto, Sina Ribak: Alchemic Cooking, lecture performance, festival MATTER OF FLUX, Art Laboratory Berlin, 2023, photo: ALB
Chiara Garbellotto, Sina Ribak: Alchemic Cooking, lecture performance, festival MATTER OF FLUX, Art Laboratory Berlin, 2023, photo: ALB
Chiara Garbellotto, Sina Ribak: Alchemic Cooking, lecture performance, festival MATTER OF FLUX, Art Laboratory Berlin, 2023, photo: ALB
Chiara Garbellotto, Sina Ribak: Alchemic Cooking, lecture performance, festival MATTER OF FLUX, Art Laboratory Berlin, 2023, photo: ALB
Chiara Garbellotto, Sina Ribak: Alchemic Cooking, lecture performance, festival MATTER OF FLUX, Art Laboratory Berlin, 2023, photo: ALB
Chiara Garbellotto, Sina Ribak: Alchemic Cooking, lecture performance, festival MATTER OF FLUX, Art Laboratory Berlin, 2023, photo: ALB
Chiara Garbellotto, Sina Ribak: Alchemic Cooking, lecture performance, festival MATTER OF FLUX, Art Laboratory Berlin, 2023, photo: ALB
Chiara Garbellotto, Sina Ribak: Alchemic Cooking, lecture performance, festival MATTER OF FLUX, Art Laboratory Berlin, 2023, photo: ALB
Chiara Garbellotto, Sina Ribak: Alchemic Cooking, lecture performance, festival MATTER OF FLUX, Art Laboratory Berlin, 2023, photo: ALB
Chiara Garbellotto, Sina Ribak: Alchemic Cooking, lecture performance, festival MATTER OF FLUX, Art Laboratory Berlin, 2023, photo: ALB
India Mansour, Gülşah Mursaloğlu, Cammack Lindsey, Sybille Neumeyer, Lena Fließbach, Cansu Tekin: LEAKY CYCLES Reading Group, festival MATTER OF FLUX, Art Laboratory Berlin, 2023, photo: ALB
India Mansour, Gülşah Mursaloğlu, Cammack Lindsey, Sybille Neumeyer, Lena Fließbach, Cansu Tekin: LEAKY CYCLES Reading Group, festival MATTER OF FLUX, Art Laboratory Berlin, 2023, photo: ALB
India Mansour, Gülşah Mursaloğlu, Cammack Lindsey, Sybille Neumeyer, Lena Fließbach, Cansu Tekin: LEAKY CYCLES Reading Group, festival MATTER OF FLUX, Art Laboratory Berlin, 2023, photo: ALB
India Mansour, Gülşah Mursaloğlu, Cammack Lindsey, Sybille Neumeyer, Lena Fließbach, Cansu Tekin: LEAKY CYCLES Reading Group, festival MATTER OF FLUX, Art Laboratory Berlin, 2023, photo: ALB
India Mansour, Gülşah Mursaloğlu, Cammack Lindsey, Sybille Neumeyer, Lena Fließbach, Cansu Tekin: LEAKY CYCLES Reading Group, festival MATTER OF FLUX, Art Laboratory Berlin, 2023, photo: ALB
India Mansour, Gülşah Mursaloğlu, Cammack Lindsey, Sybille Neumeyer, Lena Fließbach, Cansu Tekin: LEAKY CYCLES Reading Group, festival MATTER OF FLUX, Art Laboratory Berlin, 2023, photo: ALB
India Mansour, Gülşah Mursaloğlu, Cammack Lindsey, Sybille Neumeyer, Lena Fließbach, Cansu Tekin: LEAKY CYCLES Reading Group, festival MATTER OF FLUX, Art Laboratory Berlin, 2023, photo: ALB
India Mansour, Gülşah Mursaloğlu, Cammack Lindsey, Sybille Neumeyer, Lena Fließbach, Cansu Tekin: LEAKY CYCLES Reading Group, festival MATTER OF FLUX, Art Laboratory Berlin, 2023, photo: ALB
Constanza Piña Pardo, Nicol Rivera Aro, pamela varela, Flo Razoux: Octopussyntric, workshop, festival MATTER OF FLUX, Art Laboratory Berlin, 2023, photo: ALB
Constanza Piña Pardo, Nicol Rivera Aro, pamela varela, Flo Razoux: Octopussyntric, workshop, festival MATTER OF FLUX, Art Laboratory Berlin, 2023, photo: ALB
Constanza Piña Pardo, Nicol Rivera Aro, pamela varela, Flo Razoux: Octopussyntric, workshop, festival MATTER OF FLUX, Art Laboratory Berlin, 2023, photo: ALB
Constanza Piña Pardo, Nicol Rivera Aro, pamela varela, Flo Razoux: Octopussyntric, workshop, festival MATTER OF FLUX, Art Laboratory Berlin, 2023, photo: ALB
Constanza Piña Pardo, Nicol Rivera Aro, pamela varela, Flo Razoux: Octopussyntric, workshop, festival MATTER OF FLUX, Art Laboratory Berlin, 2023, photo: ALB
Constanza Piña Pardo, Nicol Rivera Aro, pamela varela, Flo Razoux: Octopussyntric, workshop, festival MATTER OF FLUX, Art Laboratory Berlin, 2023, photo: ALB
Constanza Piña Pardo, Nicol Rivera Aro, pamela varela, Flo Razoux: Octopussyntric, workshop, festival MATTER OF FLUX, Art Laboratory Berlin, 2023, photo: ALB
Constanza Piña Pardo, Nicol Rivera Aro, pamela varela, Flo Razoux: Octopussyntric, workshop, festival MATTER OF FLUX, Art Laboratory Berlin, 2023, photo: ALB
Constanza Piña Pardo, Nicol Rivera Aro, pamela varela, Flo Razoux: Octopussyntric, workshop, festival MATTER OF FLUX, Art Laboratory Berlin, 2023, photo: ALB
Constanza Piña Pardo, Nicol Rivera Aro, pamela varela, Flo Razoux: Octopussyntric, workshop, festival MATTER OF FLUX, Art Laboratory Berlin, 2023, photo: ALB
Selen Solak, Marianna Szczygielska, Baldeep Kaur, Hanwen Zhang: CRITICAL HISTORY OF TECHNOLOGY Zine Making, workshop, festival MATTER OF FLUX, Art Laboratory Berlin, 2023, photo: ALB
Selen Solak, Marianna Szczygielska, Baldeep Kaur, Hanwen Zhang: CRITICAL HISTORY OF TECHNOLOGY Zine Making, workshop, festival MATTER OF FLUX, Art Laboratory Berlin, 2023, photo: ALB
Selen Solak, Marianna Szczygielska, Baldeep Kaur, Hanwen Zhang: CRITICAL HISTORY OF TECHNOLOGY Zine Making, workshop, festival MATTER OF FLUX, Art Laboratory Berlin, 2023, photo: ALB
Selen Solak, Marianna Szczygielska, Baldeep Kaur, Hanwen Zhang: CRITICAL HISTORY OF TECHNOLOGY Zine Making, workshop, festival MATTER OF FLUX, Art Laboratory Berlin, 2023, photo: ALB
Selen Solak, Marianna Szczygielska, Baldeep Kaur, Hanwen Zhang: CRITICAL HISTORY OF TECHNOLOGY Zine Making, workshop, festival MATTER OF FLUX, Art Laboratory Berlin, 2023, photo: ALB
Selen Solak, Marianna Szczygielska, Baldeep Kaur, Hanwen Zhang: CRITICAL HISTORY OF TECHNOLOGY Zine Making, workshop, festival MATTER OF FLUX, Art Laboratory Berlin, 2023, photo: ALB
Selen Solak, Marianna Szczygielska, Baldeep Kaur, Hanwen Zhang: CRITICAL HISTORY OF TECHNOLOGY Zine Making, workshop, festival MATTER OF FLUX, Art Laboratory Berlin, 2023, photo: ALB
Selen Solak, Marianna Szczygielska, Baldeep Kaur, Hanwen Zhang: CRITICAL HISTORY OF TECHNOLOGY Zine Making, workshop, festival MATTER OF FLUX, Art Laboratory Berlin, 2023, photo: ALB
India Mansour, Gülşah Mursaloğlu, Cammack Lindsey, Sybille Neumeyer, Lena Fließbach, Cansu Tekin: COMPOST Zine Lounge, workshop, festival MATTER OF FLUX, Art Laboratory Berlin, 2023, photo: ALB
India Mansour, Gülşah Mursaloğlu, Cammack Lindsey, Sybille Neumeyer, Lena Fließbach, Cansu Tekin: COMPOST Zine Lounge, workshop, festival MATTER OF FLUX, Art Laboratory Berlin, 2023, photo: ALB
India Mansour, Gülşah Mursaloğlu, Cammack Lindsey, Sybille Neumeyer, Lena Fließbach, Cansu Tekin: COMPOST Zine Lounge, workshop, festival MATTER OF FLUX, Art Laboratory Berlin, 2023, photo: ALB
India Mansour, Gülşah Mursaloğlu, Cammack Lindsey, Sybille Neumeyer, Lena Fließbach, Cansu Tekin: COMPOST Zine Lounge, workshop, festival MATTER OF FLUX, Art Laboratory Berlin, 2023, photo: ALB
India Mansour, Gülşah Mursaloğlu, Cammack Lindsey, Sybille Neumeyer, Lena Fließbach, Cansu Tekin: COMPOST Zine Lounge, workshop, festival MATTER OF FLUX, Art Laboratory Berlin, 2023, photo: ALB
India Mansour, Gülşah Mursaloğlu, Cammack Lindsey, Sybille Neumeyer, Lena Fließbach, Cansu Tekin: COMPOST Zine Lounge, workshop, festival MATTER OF FLUX, Art Laboratory Berlin, 2023, photo: ALB
India Mansour, Gülşah Mursaloğlu, Cammack Lindsey, Sybille Neumeyer, Lena Fließbach, Cansu Tekin: COMPOST Zine Lounge, workshop, festival MATTER OF FLUX, Art Laboratory Berlin, 2023, photo: ALB
India Mansour, Gülşah Mursaloğlu, Cammack Lindsey, Sybille Neumeyer, Lena Fließbach, Cansu Tekin: COMPOST Zine Lounge, workshop, festival MATTER OF FLUX, Art Laboratory Berlin, 2023, photo: ALB
Anne Hölck, Nicola Maria Hochkeppel, Aslı Dinç: Instant Storytelling Sessions, festival MATTER OF FLUX, Art Laboratory Berlin, 2023, photo: ALB
Anne Hölck, Nicola Maria Hochkeppel, Aslı Dinç: Instant Storytelling Sessions, festival MATTER OF FLUX, Art Laboratory Berlin, 2023, photo: ALB
Anne Hölck, Nicola Maria Hochkeppel, Aslı Dinç: Instant Storytelling Sessions, festival MATTER OF FLUX, Art Laboratory Berlin, 2023, photo: ALB
Anne Hölck, Nicola Maria Hochkeppel, Aslı Dinç: Instant Storytelling Sessions, festival MATTER OF FLUX, Art Laboratory Berlin, 2023, photo: ALB
Anne Hölck, Nicola Maria Hochkeppel, Aslı Dinç: Instant Storytelling Sessions, festival MATTER OF FLUX, Art Laboratory Berlin, 2023, photo: ALB
Anne Hölck, Nicola Maria Hochkeppel, Aslı Dinç: Instant Storytelling Sessions, festival MATTER OF FLUX, Art Laboratory Berlin, 2023, photo: ALB
Anne Hölck, Nicola Maria Hochkeppel, Aslı Dinç: Instant Storytelling Sessions, festival MATTER OF FLUX, Art Laboratory Berlin, 2023, photo: ALB
Anne Hölck, Nicola Maria Hochkeppel, Aslı Dinç: Instant Storytelling Sessions, festival MATTER OF FLUX, Art Laboratory Berlin, 2023, photo: ALB
Anne Hölck, Nicola Maria Hochkeppel, Aslı Dinç: Instant Storytelling Sessions, festival MATTER OF FLUX, Art Laboratory Berlin, 2023, photo: ALB
Kristina Stallvik: The Fluxional Shelf, festival MATTER OF FLUX, Art Laboratory Berlin, 2023, photo: ALB
Kristina Stallvik: The Fluxional Shelf, Festival MATTER OF FLUX, Art Laboratory Berlin, 2023, Foto: Kristina Stallvik
Kristina Stallvik: The Fluxional Shelf, Festival MATTER OF FLUX, Art Laboratory Berlin, 2023, Foto: Kristina Stallvik
Kristina Stallvik: The Fluxional Shelf, Festival MATTER OF FLUX, Art Laboratory Berlin, 2023, Foto: Kristina Stallvik
Kristina Stallvik: The Fluxional Shelf, Festival MATTER OF FLUX, Art Laboratory Berlin, 2023, Foto: Kristina Stallvik
Kristina Stallvik: The Fluxional Shelf, Festival MATTER OF FLUX, Art Laboratory Berlin, 2023, Foto: Kristina Stallvik
Freitag, 16 June 2023 @ PA58
TAGESPASS HIER ERHÄLTLICH (DIE ANMELDUNG FÜR DIE EINZELNEN VERANSTALTUNGEN BEGINNT AM MORGEN DESSELBEN TAGES VOR ORT)!
9:00 – 9:45 Registrierung vor Ort (auch für die Nachmittags-Veranstaltungen!)
9:00 – 10:00
LEAKY CYCLES SOIL EATERS – A Geophagy Ritual
India Mansour (Biologin, Berlin), Gülşah Mursaloğlu (Künstlerin, Berlin), Cammack Lindsey (Künstlerin, Sängerin, Berlin), Sybille Neumeyer (Kuratorin, Forscherin, Berlin), Lena Fließbach (Kuratorin, Berlin), Cansu Tekin (Biologin, Berlin)
10:30 – 12:45
PLANT ENCOUNTERS. PRACTICES, SITES, COMMUNICATION Sites of Vegetal Life
Alice Cannava (Herausgeberin/ Kuratorin, Designerin/ Programmiererin, Berlin), Lisa Bell Weisdorf (Künstlerin, Berlin), Kaethe Wenzel (Künstlerin, Forscherin, Berlin), Susanne Schmitt (Künstlerin, Forscherin, Berlin)
— 13:00 – 14:00 MITTAGSPAUSE —
Veranstaltungen zur Auswahl (morgens vor Ort registrieren)
14:00 – 17:00
PLANT ENCOUNTERS. PRACTICES, SITES, COMMUNICATION MicroCosMOSS Workshop
Susanne Jaschko (Kunsthistorikerin, Kuratorin, Kulturmanagerin, Dozentin, Kommunikatorin, Berlin), Jacky Hess (Biologin, Berlin), Eva-Fiore Kovacovsky (Künstlerin, Berlin), Lucy Powell (Künstlerin, Forscherin, Berlin)
14:00 – 17:00
TECHNOLOGIES/ SENSORS/ INTERFACES OCTOPUSSYNTRIC Workshop (Part 2 of 2)
Constanza Piña Pardo (Künstlerin, Tänzerin, Forscherin, Berlin/ Chile), Nicol Rivera Aro (Kuratorin, Forscherin, Dramaturgin, Berlin/ Chile), pamela varela (Künstlerin, Activistin, Poetin, Berlin/ Mexico), Flo Razoux (Biologin, Dozentin, Berlin/ Marseille)
16:00 – 17:30
LEAKY CYCLES INFINITE RETURNS – A Role-playing Activity
India Mansour (Biologin, Berlin), Gülşah Mursaloğlu (Künstlerin, Berlin), Cammack Lindsey (Künstlerin, Sängerin, Berlin), Sybille Neumeyer (Kuratorin, Forscherin, Berlin), Lena Fließbach (Kuratorin, Berlin), Cansu Tekin (Biologin, Berlin)
17:00 – 18:00
CRITICAL HISTORY OF TECHNOLOGY Glitter Kitchen Workshop
Selen Solak (Experimentelle Forscherin, Berlin), Marianna Szczygielska (Forscherin für Feministische Wissenschaftsgeschichte), Baldeep Kaur (Forscherin für Englische Literatur und Science & Technology Studies, Berlin)
13:00 – 16:00 Ongoing activities
LEAKY CYCLES COMPOST Zine Lounge
India Mansour (Biologin, Berlin), Gülşah Mursaloğlu (Künstlerin, Berlin), Cammack Lindsey (Künstlerin, Sängerin, Berlin), Sybille Neumeyer (Kuratorin, Forscherin, Berlin), Lena Fließbach (Kuratorin, Berlin), Cansu Tekin (Biologin, Berlin)
14:00 – 18:00 Laufende Veranstaltungen
ALTERNATIVE KNOWLEDGE PRODUCTION Instant Storytelling sessions
Anne Hölck (Szenographin, Kuratorin, Berlin), Nicola Maria Hochkeppel (Kulturproduzentin, Gesundheitsberaterin, Berlin), Petja Ivanova (Künstlerin, Dozentin, Berlin), Aslı Dinç (Künstlerin, Forscherin, Berlin)
ALTERNATIVE KNOWLEDGE PRODUCTION The Fluxional Shelf
Kristina Stallvik (Künstlerin, Forscherin, Berlin/ New York)
18:00 TRANS CHOIR singt
Außerhalb des Festivalortes
21:00 – Open End
CLUB Night @ Panke Club
Mit einer Live-Präsentation des OCTOPUSSYNTRIC Workshops (MoF Festival)
Später mit DJ Mieko Suzuki & Daniela Huerta aka DJ Baby Vulture!
ZAHLREICHE BILDER vom Freitag, dem zweiten Festival-Tag:
India Mansour, Gülşah Mursaloğlu, Cammack Lindsey, Sybille Neumeyer, Lena Fließbach, Cansu Tekin: SOIL EATERS – A Geophagy Ritual, festival MATTER OF FLUX, Art Laboratory Berlin, 2023, photo: ALB
India Mansour, Gülşah Mursaloğlu, Cammack Lindsey, Sybille Neumeyer, Lena Fließbach, Cansu Tekin: SOIL EATERS – A Geophagy Ritual, festival MATTER OF FLUX, Art Laboratory Berlin, 2023, photo: ALB
India Mansour, Gülşah Mursaloğlu, Cammack Lindsey, Sybille Neumeyer, Lena Fließbach, Cansu Tekin: SOIL EATERS – A Geophagy Ritual, festival MATTER OF FLUX, Art Laboratory Berlin, 2023, photo: ALB
India Mansour, Gülşah Mursaloğlu, Cammack Lindsey, Sybille Neumeyer, Lena Fließbach, Cansu Tekin: SOIL EATERS – A Geophagy Ritual, festival MATTER OF FLUX, Art Laboratory Berlin, 2023, photo: ALB
India Mansour, Gülşah Mursaloğlu, Cammack Lindsey, Sybille Neumeyer, Lena Fließbach, Cansu Tekin: SOIL EATERS – A Geophagy Ritual, festival MATTER OF FLUX, Art Laboratory Berlin, 2023, photo: ALB
India Mansour, Gülşah Mursaloğlu, Cammack Lindsey, Sybille Neumeyer, Lena Fließbach, Cansu Tekin: SOIL EATERS – A Geophagy Ritual, festival MATTER OF FLUX, Art Laboratory Berlin, 2023, photo: ALB
India Mansour, Gülşah Mursaloğlu, Cammack Lindsey, Sybille Neumeyer, Lena Fließbach, Cansu Tekin: SOIL EATERS – A Geophagy Ritual, festival MATTER OF FLUX, Art Laboratory Berlin, 2023, photo: ALB
India Mansour, Gülşah Mursaloğlu, Cammack Lindsey, Sybille Neumeyer, Lena Fließbach, Cansu Tekin: SOIL EATERS – A Geophagy Ritual, festival MATTER OF FLUX, Art Laboratory Berlin, 2023, photo: ALB
India Mansour, Gülşah Mursaloğlu, Cammack Lindsey, Sybille Neumeyer, Lena Fließbach, Cansu Tekin: SOIL EATERS – A Geophagy Ritual, festival MATTER OF FLUX, Art Laboratory Berlin, 2023, photo: ALB
Alice Cannava, Lisa Bell Weisdorf, Käthe Wenzel, Susanne Schmitt: Sites of Vegetal Life, lecture performance, festival MATTER OF FLUX, Art Laboratory Berlin, 2023, photo: ALB
Alice Cannava, Lisa Bell Weisdorf, Käthe Wenzel, Susanne Schmitt: Sites of Vegetal Life, Alice Cannava speaking, lecture performance, festival MATTER OF FLUX, Art Laboratory Berlin, 2023, photo: ALB
Alice Cannava, Lisa Bell Weisdorf, Käthe Wenzel, Susanne Schmitt: Sites of Vegetal Life, Käthe Wenzel speaking, lecture performance, festival MATTER OF FLUX, Art Laboratory Berlin, 2023, photo: ALB
Alice Cannava, Lisa Bell Weisdorf, Käthe Wenzel, Susanne Schmitt: Sites of Vegetal Life, Käthe Wenzel speaking, lecture performance, festival MATTER OF FLUX, Art Laboratory Berlin, 2023, photo: ALB
Alice Cannava, Lisa Bell Weisdorf, Käthe Wenzel, Susanne Schmitt: Sites of Vegetal Life, lecture performance, festival MATTER OF FLUX, Art Laboratory Berlin, 2023, photo: ALB
Alice Cannava, Lisa Bell Weisdorf, Käthe Wenzel, Susanne Schmitt: Sites of Vegetal Life, lecture performance, festival MATTER OF FLUX, Art Laboratory Berlin, 2023, photo: ALB
Alice Cannava, Lisa Bell Weisdorf, Käthe Wenzel, Susanne Schmitt: Sites of Vegetal Life, Käthe Wenzel presenting, lecture performance, festival MATTER OF FLUX, Art Laboratory Berlin, 2023, photo: ALB
Alice Cannava, Lisa Bell Weisdorf, Käthe Wenzel, Susanne Schmitt: Sites of Vegetal Life, Susanne Schmitt speaking, lecture performance, festival MATTER OF FLUX, Art Laboratory Berlin, 2023, photo: ALB
Alice Cannava, Lisa Bell Weisdorf, Käthe Wenzel, Susanne Schmitt: Sites of Vegetal Life, lecture performance, festival MATTER OF FLUX, Art Laboratory Berlin, 2023, photo: ALB
Alice Cannava, Lisa Bell Weisdorf, Käthe Wenzel, Susanne Schmitt: Sites of Vegetal Life, lecture performance, festival MATTER OF FLUX, Art Laboratory Berlin, 2023, photo: ALB
Alice Cannava, Lisa Bell Weisdorf, Käthe Wenzel, Susanne Schmitt: Sites of Vegetal Life, lecture performance, festival MATTER OF FLUX, Art Laboratory Berlin, 2023, photo: ALB
Susanne Jaschko, Jacky Hess, Eva-Fiore Kovacovsky, Lucy Powell: MicroCossMOSS, workshop, festival MATTER OF FLUX, Art Laboratory Berlin, 2023, photo: ALB
Susanne Jaschko, Jacky Hess, Eva-Fiore Kovacovsky, Lucy Powell: MicroCossMOSS, workshop, festival MATTER OF FLUX, Art Laboratory Berlin, 2023, photo: ALB
Susanne Jaschko, Jacky Hess, Eva-Fiore Kovacovsky, Lucy Powell: MicroCossMOSS, workshop, festival MATTER OF FLUX, Art Laboratory Berlin, 2023, photo: ALB
Susanne Jaschko, Jacky Hess, Eva-Fiore Kovacovsky, Lucy Powell: MicroCossMOSS, workshop, festival MATTER OF FLUX, Art Laboratory Berlin, 2023, photo: ALB
Susanne Jaschko, Jacky Hess, Eva-Fiore Kovacovsky, Lucy Powell: MicroCossMOSS, workshop, festival MATTER OF FLUX, Art Laboratory Berlin, 2023, photo: ALB
Susanne Jaschko, Jacky Hess, Eva-Fiore Kovacovsky, Lucy Powell: MicroCossMOSS, workshop, festival MATTER OF FLUX, Art Laboratory Berlin, 2023, photo: ALB
Susanne Jaschko, Jacky Hess, Eva-Fiore Kovacovsky, Lucy Powell: MicroCossMOSS, workshop, festival MATTER OF FLUX, Art Laboratory Berlin, 2023, photo: ALB
Susanne Jaschko, Jacky Hess, Eva-Fiore Kovacovsky, Lucy Powell: MicroCossMOSS, workshop, festival MATTER OF FLUX, Art Laboratory Berlin, 2023, photo: ALB
Susanne Jaschko, Jacky Hess, Eva-Fiore Kovacovsky, Lucy Powell: MicroCossMOSS, workshop, festival MATTER OF FLUX, Art Laboratory Berlin, 2023, photo: ALB
Susanne Jaschko, Jacky Hess, Eva-Fiore Kovacovsky, Lucy Powell: MicroCossMOSS, workshop, festival MATTER OF FLUX, Art Laboratory Berlin, 2023, photo: ALB
Susanne Jaschko, Jacky Hess, Eva-Fiore Kovacovsky, Lucy Powell: MicroCossMOSS, workshop, festival MATTER OF FLUX, Art Laboratory Berlin, 2023, photo: ALB
Susanne Jaschko, Jacky Hess, Eva-Fiore Kovacovsky, Lucy Powell: MicroCossMOSS, workshop, festival MATTER OF FLUX, Art Laboratory Berlin, 2023, photo: ALB
India Mansour, Gülşah Mursaloğlu, Cammack Lindsey, Sybille Neumeyer, Lena Fließbach, Cansu Tekin: INFINITE RETURNS – A Role-playing Activity, festival MATTER OF FLUX, Art Laboratory Berlin, 2023, photo: ALB
India Mansour, Gülşah Mursaloğlu, Cammack Lindsey, Sybille Neumeyer, Lena Fließbach, Cansu Tekin: INFINITE RETURNS – A Role-playing Activity, festival MATTER OF FLUX, Art Laboratory Berlin, 2023, photo: ALB
India Mansour, Gülşah Mursaloğlu, Cammack Lindsey, Sybille Neumeyer, Lena Fließbach, Cansu Tekin: INFINITE RETURNS – A Role-playing Activity, festival MATTER OF FLUX, Art Laboratory Berlin, 2023, photo: ALB
India Mansour, Gülşah Mursaloğlu, Cammack Lindsey, Sybille Neumeyer, Lena Fließbach, Cansu Tekin: INFINITE RETURNS – A Role-playing Activity, festival MATTER OF FLUX, Art Laboratory Berlin, 2023, photo: ALB
India Mansour, Gülşah Mursaloğlu, Cammack Lindsey, Sybille Neumeyer, Lena Fließbach, Cansu Tekin: INFINITE RETURNS – A Role-playing Activity, festival MATTER OF FLUX, Art Laboratory Berlin, 2023, photo: ALB
Selen Solak, Marianna Szczygielska, Baldeep Kaur: Glitter Kitchen, workshop, festival MATTER OF FLUX, Art Laboratory Berlin, 2023, photo: ALB
Selen Solak, Marianna Szczygielska, Baldeep Kaur: Glitter Kitchen, workshop, festival MATTER OF FLUX, Art Laboratory Berlin, 2023, photo: ALB
Selen Solak, Marianna Szczygielska, Baldeep Kaur: Glitter Kitchen, workshop, festival MATTER OF FLUX, Art Laboratory Berlin, 2023, photo: ALB
Selen Solak, Marianna Szczygielska, Baldeep Kaur: Glitter Kitchen, workshop, festival MATTER OF FLUX, Art Laboratory Berlin, 2023, photo: ALB
Selen Solak, Marianna Szczygielska, Baldeep Kaur: Glitter Kitchen, workshop, festival MATTER OF FLUX, Art Laboratory Berlin, 2023, photo: ALB
Selen Solak, Marianna Szczygielska, Baldeep Kaur: Glitter Kitchen, workshop, festival MATTER OF FLUX, Art Laboratory Berlin, 2023, photo: ALB
Selen Solak, Marianna Szczygielska, Baldeep Kaur: Glitter Kitchen, workshop, festival MATTER OF FLUX, Art Laboratory Berlin, 2023, photo: ALB
Selen Solak, Marianna Szczygielska, Baldeep Kaur: Glitter Kitchen, workshop, festival MATTER OF FLUX, Art Laboratory Berlin, 2023, photo: ALB
Selen Solak, Marianna Szczygielska, Baldeep Kaur: Glitter Kitchen, workshop, festival MATTER OF FLUX, Art Laboratory Berlin, 2023, photo: ALB
India Mansour, Gülşah Mursaloğlu, Cammack Lindsey, Sybille Neumeyer, Lena Fließbach, Cansu Tekin: COMPOST Zine Lounge, workshop, festival MATTER OF FLUX, Art Laboratory Berlin, 2023, photo: ALB
India Mansour, Gülşah Mursaloğlu, Cammack Lindsey, Sybille Neumeyer, Lena Fließbach, Cansu Tekin: COMPOST Zine Lounge, workshop, festival MATTER OF FLUX, Art Laboratory Berlin, 2023, photo: ALB
India Mansour, Gülşah Mursaloğlu, Cammack Lindsey, Sybille Neumeyer, Lena Fließbach, Cansu Tekin: COMPOST Zine Lounge, workshop, festival MATTER OF FLUX, Art Laboratory Berlin, 2023, photo: ALB
Anne Hölck, Nicola Maria Hochkeppel, Aslı Dinç: Instant Storytelling Sessions, festival MATTER OF FLUX, Art Laboratory Berlin, 2023, photo: ALB
Anne Hölck, Nicola Maria Hochkeppel, Aslı Dinç: Instant Storytelling Sessions, festival MATTER OF FLUX, Art Laboratory Berlin, 2023, photo: ALB
Anne Hölck, Nicola Maria Hochkeppel, Aslı Dinç: Instant Storytelling Sessions, festival MATTER OF FLUX, Art Laboratory Berlin, 2023, photo: ALB
Kristina Stallvik: The Fluxional Shelf, festival MATTER OF FLUX, Art Laboratory Berlin, 2023, photo: ALB
Kristina Stallvik: The Fluxional Shelf, festival MATTER OF FLUX, Art Laboratory Berlin, 2023, photo: ALB
Kristina Stallvik: The Fluxional Shelf, Festival MATTER OF FLUX, Art Laboratory Berlin, 2023, Foto: Kristina Stallvik
Samstag, 17. Juni 2023 @ PA58
MELDEN SIE SICH FÜR JEDE VERANSTALTUNG DIESES TAGES EINZELN AN – HIER!
11:30 – 16:30 Open Café Hangout
13:00 – 16:00
ALTERNATIVE KNOWLEDGE PRODUCTION Liquifying Language Workshop
Annika Haas (Medientheoretikerin, Autorin, Berlin)
14:00 – 17:00
SMELL Workshop
Lyndsey Walsh (Künstlerin, Forscherin, Berlin), Alanna Lynch (Künstlerin, Forscherin, Berlin)
13:00 – 16:30 Laufende Aktivitäten
ALTERNATIVE KNOWLEDGE PRODUCTION Instant Storytelling sessions
Anne Hölck (Szenographin, Kuratorin, Berlin), Nicola Maria Hochkeppel (Kulturproduzentin, Gesundheitsberaterin, Berlin), Petja Ivanova (Künstlerin, Dozentin, Berlin), Aslı Dinç (Künstlerin, Forscherin, Berlin)
(Festivalteilnehmer:innen vom 15. oder 16. Juni könen teilnehmen)
ALTERNATIVE KNOWLEDGE PRODUCTION The Fluxional Shelf
Kristina Stallvik (Künstlerin, Forscherin, Berlin/ New York)
(Festivalteilnehmer:innen vom 15. oder 16. Juni könen teilnehmen)
Außerhalb des Festivalortes
15:30 – 16:30
LAB-BESUCH Pflanzenökologie, FU Berlin
Mit India Mansour (Biologin, Berlin)
21:00 – 21:40
AUSSTELLUNGSBESUCH tissues of care (wt), Charité
Mit Sybille Neumeyer (Künstlerin, Forscherin, Berlin)
ZAHLREICHE BILDER vom Samstag, dem dritten Festival-Tag:
Annika Haas: Liquifying Language, workshop, festival MATTER OF FLUX, Art Laboratory Berlin, 2023, photo: ALB
Annika Haas: Liquifying Language, workshop, festival MATTER OF FLUX, Art Laboratory Berlin, 2023, photo: ALB
Annika Haas: Liquifying Language, workshop, festival MATTER OF FLUX, Art Laboratory Berlin, 2023, photo: ALB
Annika Haas: Liquifying Language, workshop, festival MATTER OF FLUX, Art Laboratory Berlin, 2023, photo: ALB
Annika Haas: Liquifying Language, workshop, festival MATTER OF FLUX, Art Laboratory Berlin, 2023, photo: ALB
Annika Haas: Liquifying Language, workshop, festival MATTER OF FLUX, Art Laboratory Berlin, 2023, photo: ALB
Annika Haas: Liquifying Language, workshop, festival MATTER OF FLUX, Art Laboratory Berlin, 2023, photo: ALB
Annika Haas: Liquifying Language, workshop, festival MATTER OF FLUX, Art Laboratory Berlin, 2023, photo: ALB
Lyndsey Walsh, Alanna Lynch: Conjuring Stench. SMELL workshop, festival MATTER OF FLUX, Art Laboratory Berlin, 2023, photo: ALB
Lyndsey Walsh, Alanna Lynch: Conjuring Stench. SMELL workshop, festival MATTER OF FLUX, Art Laboratory Berlin, 2023, photo: ALB
Lyndsey Walsh, Alanna Lynch: Conjuring Stench. SMELL workshop, festival MATTER OF FLUX, Art Laboratory Berlin, 2023, photo: ALB
Lyndsey Walsh, Alanna Lynch: Conjuring Stench. SMELL workshop, festival MATTER OF FLUX, Art Laboratory Berlin, 2023, photo: ALB
Lyndsey Walsh, Alanna Lynch: Conjuring Stench. SMELL workshop, festival MATTER OF FLUX, Art Laboratory Berlin, 2023, photo: ALB
Lyndsey Walsh, Alanna Lynch: Conjuring Stench. SMELL workshop, festival MATTER OF FLUX, Art Laboratory Berlin, 2023, photo: ALB
Lyndsey Walsh, Alanna Lynch: Conjuring Stench. SMELL workshop, festival MATTER OF FLUX, Art Laboratory Berlin, 2023, photo: ALB
Lyndsey Walsh, Alanna Lynch: Conjuring Stench. SMELL workshop, festival MATTER OF FLUX, Art Laboratory Berlin, 2023, photo: ALB
Lyndsey Walsh, Alanna Lynch: Conjuring Stench. SMELL workshop, festival MATTER OF FLUX, Art Laboratory Berlin, 2023, photo: ALB
Lyndsey Walsh, Alanna Lynch: Conjuring Stench. SMELL workshop, festival MATTER OF FLUX, Art Laboratory Berlin, 2023, photo: ALB
Anne Hölck, Nicola Maria Hochkeppel, Aslı Dinç: Instant Storytelling Sessions, festival MATTER OF FLUX, Art Laboratory Berlin, 2023, photo: ALB
Anne Hölck, Nicola Maria Hochkeppel, Aslı Dinç: Instant Storytelling Sessions, festival MATTER OF FLUX, Art Laboratory Berlin, 2023, photo: ALB
Anne Hölck, Nicola Maria Hochkeppel, Aslı Dinç: Instant Storytelling Sessions, festival MATTER OF FLUX, Art Laboratory Berlin, 2023, photo: ALB
Kristina Stallvik: The Fluxional Shelf, festival MATTER OF FLUX, Art Laboratory Berlin, 2023, photo: ALB
Kristina Stallvik: The Fluxional Shelf, festival MATTER OF FLUX, Art Laboratory Berlin, 2023, photo: ALB
Kristina Stallvik: The Fluxional Shelf, Festival MATTER OF FLUX, Art Laboratory Berlin, 2023, Foto: Kristina Stallvik
VISITS, festival MATTER OF FLUX, Art Laboratory Berlin, 2023, photo: Jessica Ullrich
India Mansour: LAB VISIT, at Plant Ecologies, Institute of Biology, Freie Universität Berlin, here Matthias Rillig speaking, festival MATTER OF FLUX, Art Laboratory Berlin, 2023, photo: Jessica Ullrich
India Mansour: LAB VISIT, at Plant Ecologies, Institute of Biology, Freie Universität Berlin, festival MATTER OF FLUX, Art Laboratory Berlin, 2023, photo: Jessica Ullrich
India Mansour: LAB VISIT, at Plant Ecologies, Institute of Biology, Freie Universität Berlin, festival MATTER OF FLUX, Art Laboratory Berlin, 2023, photo: Jessica Ullrich
India Mansour: LAB VISIT, at Plant Ecologies, Institute of Biology, Freie Universität Berlin, festival MATTER OF FLUX, Art Laboratory Berlin, 2023, photo: Jessica Ullrich
India Mansour: LAB VISIT, at Plant Ecologies, Institute of Biology, Freie Universität Berlin, festival MATTER OF FLUX, Art Laboratory Berlin, 2023, photo: Jessica Ullrich
India Mansour: LAB VISIT, at Plant Ecologies, Institute of Biology, Freie Universität Berlin, festival MATTER OF FLUX, Art Laboratory Berlin, 2023, photo: Jessica Ullrich
Sybille Neumeyer: tissues of care, exhibition visit, Charité, festival MATTER OF FLUX, Art Laboratory Berlin, 2023, photo: Jessica Ullrich
Sybille Neumeyer: tissues of care, exhibition visit, Charité, festival MATTER OF FLUX, Art Laboratory Berlin, 2023, photo: Jessica Ullrich
Sybille Neumeyer: tissues of care, exhibition visit, Charité, festival MATTER OF FLUX, Art Laboratory Berlin, 2023, photo: Jessica Ullrich
Sybille Neumeyer: tissues of care, exhibition visit, Charité, festival MATTER OF FLUX, Art Laboratory Berlin, 2023, photo: Jessica Ullrich
Sybille Neumeyer: tissues of care, exhibition visit, Charité, festival MATTER OF FLUX, Art Laboratory Berlin, 2023, photo: Jessica Ullrich
Sonntag, 18. Juni 2023 @ PA58
MELDEN SIE SICH FÜR JEDE VERANSTALTUNG DIESES TAGES EINZELN AN – HIER!
11:30 – 16:30 | Open Café Hangout
12:00 – 15:00
HYDRO-RELATIONS Vessels for Water Workshop
Jemma Woolmore (Künstlerin, Forscherin, Berlin), Lena Johanna Reisner (Kuratorin, Autorin, Berlin), Nayeli Vega (Künstlerin, Designerin, Forscherin, Berlin), Sarah Hermanutz (Künstlerin, Berlin)
13:00 – 15:00
CRITICAL HISTORY OF TECHNOLOGY Zine Making Workshop (Part 2 of 2)
Selen Solak (Experimentelle Forscherin, Berlin), Marianna Szczygielska (Forscherin für Feministische Wissenschaftsgeschichte), Baldeep Kaur (Forscherin für Englische Literatur und Science & Technology Studies, Berlin), Hanwen Zhang (Kuratorin, Forscherin, Berlin/ China)
15:30 – 16:30
PLENUM — MATTER OF FLUX Get-Together
Abschlussdiskussion; Gespräch über folgende Schritte für ein MATTER OF FLUX-Netzwerk
(Festivalteilnehmer:innen vom 15. oder 16. Juni und MoF-Netzwerk-Kolleginnen könen teilnehmen)
12:00 – 16:00 Laufende Aktivitäten
ALTERNATIVE KNOWLEDGE PRODUCTION Instant Storytelling sessions
Anne Hölck (Szenographin, Kuratorin, Berlin), Nicola Maria Hochkeppel (Kulturproduzentin, Gesundheitsberaterin, Berlin), Petja Ivanova (Künstlerin, Dozentin, Berlin), Aslı Dinç (Künstlerin, Forscherin, Berlin)
(Festivalteilnehmer:innen vom 15. oder 16. Juni könen teilnehmen)
ALTERNATIVE KNOWLEDGE PRODUCTION The Fluxional Shelf
Kristina Stallvik (Küsntlerin, Forscherin, Berlin/ New York)
(Festivalteilnehmer:innen vom 15. oder 16. Juni könen teilnehmen)
Außerhalb des Festivalortes
13:00 – 13:45 and 14:00 – 14:45 (2 slots)
ARTIST STUDIO VISIT Fluid Art Practices. Ein Besuch im Studio von Margherita Pevere und Theresa Schubert
Nicht begrenzt für Frauen/ FLINTA*, sondern offen für alle!
14:00 – 15:00 and 16:00 – 17:00 (2 slots)
ARTIST STUDIO VISIT mit Cammack Lindsey (Künstlerin, Forscherin, Berlin)
Nicht begrenzt für Frauen/ FLINTA*, sondern offen für alle!
ZAHLREICHE BILDER vom Sonntag, dem vierten und letzten Festival-Tag:
Jemma Woolmore, Lena Johanna Reisner, Nayeli Vega, Sarah Hermanutz: Vessels for Water, workshop, festival MATTER OF FLUX, Art Laboratory Berlin, 2023, photo: ALB
Jemma Woolmore, Lena Johanna Reisner, Nayeli Vega, Sarah Hermanutz: Vessels for Water, workshop, festival MATTER OF FLUX, Art Laboratory Berlin, 2023, photo: ALB
Jemma Woolmore, Lena Johanna Reisner, Nayeli Vega, Sarah Hermanutz: Vessels for Water, workshop, festival MATTER OF FLUX, Art Laboratory Berlin, 2023, photo: ALB
Jemma Woolmore, Lena Johanna Reisner, Nayeli Vega, Sarah Hermanutz: Vessels for Water, workshop, festival MATTER OF FLUX, Art Laboratory Berlin, 2023, photo: ALB
Jemma Woolmore, Lena Johanna Reisner, Nayeli Vega, Sarah Hermanutz: Vessels for Water, workshop, festival MATTER OF FLUX, Art Laboratory Berlin, 2023, photo: ALB
Jemma Woolmore, Lena Johanna Reisner, Nayeli Vega, Sarah Hermanutz: Vessels for Water, workshop, festival MATTER OF FLUX, Art Laboratory Berlin, 2023, photo: ALB
Jemma Woolmore, Lena Johanna Reisner, Nayeli Vega, Sarah Hermanutz: Vessels for Water, workshop, festival MATTER OF FLUX, Art Laboratory Berlin, 2023, photo: ALB
Jemma Woolmore, Lena Johanna Reisner, Nayeli Vega, Sarah Hermanutz: Vessels for Water, workshop, festival MATTER OF FLUX, Art Laboratory Berlin, 2023, photo: ALB
Jemma Woolmore, Lena Johanna Reisner, Nayeli Vega, Sarah Hermanutz: Vessels for Water, workshop, festival MATTER OF FLUX, Art Laboratory Berlin, 2023, photo: ALB
Jemma Woolmore, Lena Johanna Reisner, Nayeli Vega, Sarah Hermanutz: Vessels for Water, workshop, festival MATTER OF FLUX, Art Laboratory Berlin, 2023, photo: ALB
Jemma Woolmore, Lena Johanna Reisner, Nayeli Vega, Sarah Hermanutz: Vessels for Water, workshop, festival MATTER OF FLUX, Art Laboratory Berlin, 2023, photo: ALB
Jemma Woolmore, Lena Johanna Reisner, Nayeli Vega, Sarah Hermanutz: Vessels for Water, workshop, festival MATTER OF FLUX, Art Laboratory Berlin, 2023, photo: ALB
Jemma Woolmore, Lena Johanna Reisner, Nayeli Vega, Sarah Hermanutz: Vessels for Water, workshop, festival MATTER OF FLUX, Art Laboratory Berlin, 2023, photo: ALB
Jemma Woolmore, Lena Johanna Reisner, Nayeli Vega, Sarah Hermanutz: Vessels for Water, workshop, festival MATTER OF FLUX, Art Laboratory Berlin, 2023, photo: ALB
Selen Solak, Marianna Szczygielska, Baldeep Kaur, Hanwen Zhang: CRITICAL HISTORY OF TECHNOLOGY Zine Making, workshop, festival MATTER OF FLUX, Art Laboratory Berlin, 2023, photo: ALB
Selen Solak, Marianna Szczygielska, Baldeep Kaur, Hanwen Zhang: CRITICAL HISTORY OF TECHNOLOGY Zine Making, workshop, festival MATTER OF FLUX, Art Laboratory Berlin, 2023, photo: ALB
Selen Solak, Marianna Szczygielska, Baldeep Kaur, Hanwen Zhang: CRITICAL HISTORY OF TECHNOLOGY Zine Making, workshop, festival MATTER OF FLUX, Art Laboratory Berlin, 2023, photo: ALB
Anne Hölck, Nicola Maria Hochkeppel, Aslı Dinç: Instant Storytelling Sessions, festival MATTER OF FLUX, Art Laboratory Berlin, 2023, photo: ALB
Anne Hölck, Nicola Maria Hochkeppel, Aslı Dinç: Instant Storytelling Sessions, festival MATTER OF FLUX, Art Laboratory Berlin, 2023, photo: ALB
Anne Hölck, Nicola Maria Hochkeppel, Aslı Dinç: Instant Storytelling Sessions, festival MATTER OF FLUX, Art Laboratory Berlin, 2023, photo: ALB
Kristina Stallvik: The Fluxional Shelf, festival MATTER OF FLUX, Art Laboratory Berlin, 2023, photo: ALB
Kristina Stallvik: The Fluxional Shelf, festival MATTER OF FLUX, Art Laboratory Berlin, 2023, photo: ALB
Kristina Stallvik: The Fluxional Shelf, Festival MATTER OF FLUX, Art Laboratory Berlin, 2023, Foto: Kristina Stallvik
VISITS, festival MATTER OF FLUX, Art Laboratory Berlin, 2023, photo: Jessica Ullrich
Margherita Pevere, Theresa Schubert: Fluid Art Practices, artist studio visit, festival MATTER OF FLUX, Art Laboratory Berlin, 2023, photo: Jessica Ullrich
Margherita Pevere, Theresa Schubert: Fluid Art Practices, artist studio visit, festival MATTER OF FLUX, Art Laboratory Berlin, 2023, photo: Jessica Ullrich
Margherita Pevere, Theresa Schubert: Fluid Art Practices, artist studio visit, festival MATTER OF FLUX, Art Laboratory Berlin, 2023, photo: Jessica Ullrich
Margherita Pevere, Theresa Schubert: Fluid Art Practices, artist studio visit, festival MATTER OF FLUX, Art Laboratory Berlin, 2023, photo: Jessica Ullrich
Margherita Pevere, Theresa Schubert: Fluid Art Practices, artist studio visit, Margherita Pevere präsentiert, Festival MATTER OF FLUX, Art Laboratory Berlin, 2023, Foto: Jessica Ullrich
Margherita Pevere, Theresa Schubert: Fluid Art Practices, artist studio visit, Margherita Pevere präsentiert, Festival MATTER OF FLUX, Art Laboratory Berlin, 2023, Foto: Jessica Ullrich
Cammack Lindsey, artist studio visit, festival MATTER OF FLUX, Art Laboratory Berlin, 2023, photo: Jessica Ullrich
Cammack Lindsey, artist studio visit, festival MATTER OF FLUX, Art Laboratory Berlin, 2023, photo: Jessica Ullrich
Cammack Lindsey, artist studio visit, festival MATTER OF FLUX, Art Laboratory Berlin, 2023, photo: Jessica Ullrich
Cammack Lindsey, artist studio visit, festival MATTER OF FLUX, Art Laboratory Berlin, 2023, photo: Jessica Ullrich
Cammack Lindsey, artist studio visit, festival MATTER OF FLUX, Art Laboratory Berlin, 2023, photo: Jessica Ullrich
Final PLENUM DISCUSSION with participants and contributors, festival MATTER OF FLUX, Art Laboratory Berlin, 2023, photo: ALB
Final PLENUM DISCUSSION with participants and contributors, festival MATTER OF FLUX, Art Laboratory Berlin, 2023, photo: ALB
Final PLENUM DISCUSSION with participants and contributors, festival MATTER OF FLUX, Art Laboratory Berlin, 2023, photo: ALB
Final PLENUM DISCUSSION with participants and contributors, festival MATTER OF FLUX, Art Laboratory Berlin, 2023, photo: ALB
Final PLENUM DISCUSSION with participants and contributors, festival MATTER OF FLUX, Art Laboratory Berlin, 2023, photo: ALB
Final PLENUM DISCUSSION with participants and contributors, festival MATTER OF FLUX, Art Laboratory Berlin, 2023, photo: ALB
Final PLENUM DISCUSSION with participants and contributors, festival MATTER OF FLUX, Art Laboratory Berlin, 2023, photo: ALB
Final PLENUM DISCUSSION with participants and contributors, festival MATTER OF FLUX, Art Laboratory Berlin, 2023, photo: ALB
Final PLENUM DISCUSSION with participants and contributors, festival MATTER OF FLUX, Art Laboratory Berlin, 2023, photo: ALB
Participants and contributors, festival MATTER OF FLUX, Art Laboratory Berlin, 2023, photo: ALB
Das ausführliche Festival Programm mit Abstracts und Biographien ist HIER erhältlich!
AWARENESS – ZUGÄNGLICHKEIT – FÜRSORGE
Unser Ziel ist es, einen sicheren und einladenden Raum für alle zu schaffen. Das Festival MATTER OF FLUX duldet keine Form von rassistischer, sexistischer, homo-/inter-/transfeindlicher, antisemitischer, klassistischer, lookistischer oder ableistischer Diskriminierung. Wir sind offen, mehrsprachig, transnational, solidarisch und antifaschistisch. Wir sind intersektionelle Feministinnen. Wir haben einen queeren Anspruch. Wir sind kritisch gegenüber Kapitalismus und Patriarchat.
Das MATTER OF FLUX Festival wird hauptsächlich bei PA58 (Prinzenallee 58, 13359 Berlin, Festival-Eingang vom 2. Hinterhof) stattfinden. Das Gebäude ist von der Caféseite (1. Hinterhof) barrierefrei zugänglich. Es besteht die Möglichkeit der Teilnahme für sehbehinderte Menschen. Bitte kontaktieren Sie uns, falls Sie besondere Bedürfnisse haben. In unserem Team gibt es eine Person, die auf die Form dieser Unterstützung spezialisiert ist (register@artlaboratory-berlin.org).
So sehr wir uns auch wünschen, dass es nicht so wäre – COVID ist immer noch präsent, und die letzten Konferenzen in ganz Europa haben zu so genannten „Super-Spreader-Events“ geführt. Es nehmen hier auch Menschen teil, die entweder Probleme mit ihrem Immunsystem haben oder Menschen in ihrem Umfeld haben, die gefährdet sind. Nehmen Sie also bitte Rücksicht auf andere Teilnehmende. Wir empfehlen daher, dass Sie sich am Morgen der Tage, an denen Sie kommen, selbst testen. Art Laboratory Berlin kann Ihnen während des Festivals kostenlose COVID-Selbsttests anbieten. Sie können diese auch am Mittwoch, den 14. Juni von 12 – 17 Uhr am Festivalort kostenlos erhalten.
Bitte kontaktieren Sie uns: register@artlaboratory-berlin.org.